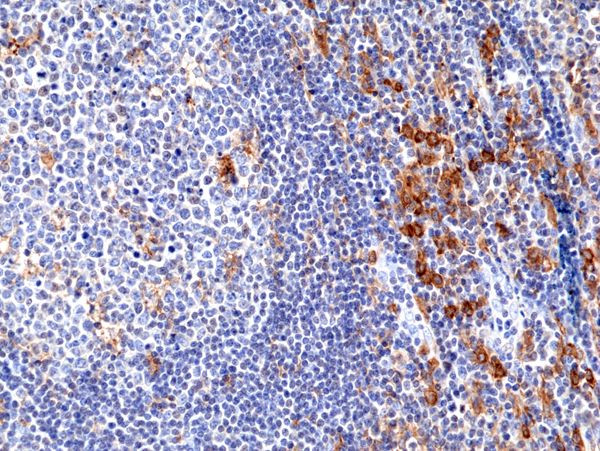
CD33 Antibody in Immunohistochemistry (Paraffin) (IHC (P))

Search
Invitrogen
CD33 Recombinant Rabbit Monoclonal Antibody (RM398)
{{$productOrderCtrl.translations['antibody.pdp.commerceCard.promotion.promotions']}}
{{$productOrderCtrl.translations['antibody.pdp.commerceCard.promotion.viewpromo']}}
{{$productOrderCtrl.translations['antibody.pdp.commerceCard.promotion.promocode']}}: {{promo.promoCode}} {{promo.promoTitle}} {{promo.promoDescription}}. {{$productOrderCtrl.translations['antibody.pdp.commerceCard.promotion.learnmore']}}
产品信息
MA5-36067
种属反应
宿主/亚型
Expression System
分类
类型
克隆号
抗原
偶联物
形式
浓度
纯化类型
保存液
内含物
保存条件
运输条件
RRID
靶标信息
CD33 is a transmembrane protein of the sialic acid-binding immunoglobulin-like lectin (Siglec) family. It belongs to the immunoreceptor tyrosine-based inhibitory motif (ITIM)-containing molecules able of recruiting protein tyrosine phosphatases SHP-1 and SHP-2 to signal assemblies, and these ITIMs are also used for ubiquitin-mediated removal of the receptor from the cell surface. CD33 is expressed on cells of myelomonocytic lineage, binds sialic acid residues in N- and O-glycans on cell surfaces, and is a therapeutic target for acute myeloid leukemia. Further, CD33 is found on granulocyte and macrophage precursors in the bone marrow, but is not on pluripotent stem cells. CD33 is also expressed on, and is a useful marker for, peripheral monocytes. CD33 is useful for distinguishing myelogenous leukemia cells from lymphoid or erythroid leukemias. Diseases associated with CD43 dysfunction include gallbladder lymphoma and extracutaneous mastocytoma.
仅用于科研。不用于诊断过程。未经明确授权不得转售。
篇参考文献 (0)
生物信息学
蛋白别名: CD33; CD33 antigen (gp67); CD33 molecule transcript; FLJ00391; gp67; lacks exon 2 but includes exon 7a; Myeloid cell surface antigen CD33; Sialic acid-binding Ig-like lectin 3; Siglec-3; unnamed protein product
基因别名: CD33; CD33rSiglec; p67; SIGLEC-3; SIGLEC3
UniProt ID: (Human) P20138
Entrez Gene ID: (Human) 945